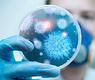

الكويت خالية من 'الكورونا'
محليات وبرلمانالمطيري: تشديد الرقابة والترصد للفيروس في البلاد لمكافحته
يوليو 6, 2014, 11:49 ص 729 مشاهدات 0
جددت رئيس لجنة التوعية الصحية بفيروس 'كورونا' بوزارة الصحة د.غالية المطيري تأكيدها بعدم تسجيل اي حالة جديدة بالفيروس منذ العام 2013 في البلاد ، لافته الى وجود تشدد في مستوى الرقابة والترصد للفيروس في دولة الكويت لمكافحته، مثمنة الجهود التي تبذلها وزارة الصحة بالتنسيق بين اللجنة الفنية لمواجهة الفيروس ، ورزارات الدولة المختلفة والشركاء في القطاعين العام والخاص والمؤسسات العلمية الدولية، خاصة منظمة الصحة العالمية.
جاء هذا في تصريح صحافي على هامش اقامت لجنة التوعية الصحية بفيروس 'كورونا' بالتنسيق مع إدارة الطيران المدني برنامجا توعويا تحت عنوان ' الوقايه من كورونا اثناء السفر والعمرة '.
وذكرت د.المطيري بأن هذا البرنامج استهدف العاملين بمطار الكويت الدولي والمسافرين المغادرين لاداء العمرة بصفة خاصة، مبينه بأن هذا البرنامج يؤكد على تعريف الموظفين والعاملين بالمطار بالإجراءات الوقائية والطبية الخاصة بالوقاية من عدوي فيروس كورونا الجديد ، وبالخصوص في موسم السفر والعمرة والحج، فضلا عن تفعيل دورهم في التعرف على الحالات المشتبهة من الأمراض الانتقالية لاحتوائها بشكل مبكر، والإسهام في نشر الوعي الصحي لدى المسافرين أو المعتمرين من الجمهور وتعزيز الالتزام بمعايير مكافحة العدوى داخل المؤسسات الحكومية.
واوضحت بأن هذا البرنامج انطلق الاسبوع الماضي من خلال تواجد مستمر لبوث لوزارة الصحة بمبني المطار عند قسم المغادرين يتم من خلاله توزيع المطبوعات الخاصة للتعريف بفيروس كورونا وطرق الوقاية منه ، والتي اصدرتها وزارة الصحة، كما تم تزويد ادارة الطيران المدني بفيلم توعوي من انتاج وزارة الصحة تم بثه في شاشات المطار وقاعات المغادرين للعمرة ، كما شمل البرنامج تعريف المشاركين بالإجراءات الوقائية الخاصة بالمعتمرين والحجاج والتي تتضمن التطعيمات ضد الأنفلونزا الموسمية والحمى الشوكية والمكورات الرئوية، الى جانب الاستشارات الطبية الخاصة بذوي الأمراض المزمنة، والإرشادات الصحية الواجب إتباعها حال الإصابة بالأعراض المرضية سواء للأمراض المعدية أو المزمنة، وكيفية التعامل معها عند السفر لأي بلد حول العالم أو لأداء العمرة، وكذلك نبذة عن فيروس كورونا المسبب لمتلازمة الشرق الأوسط التنفسية.
ولفتت الى ان هذا البرنامج يأتي استجابة للتوصيات الأخيرة الصادرة عن منظمة الصحة العالمية والتي دعت إلى قيام السلطات الصحية باستمرار برامج التوعية الصحية لسبل الوقايه من الفيروس، ووجوب توجيه النصح للأشخاص الذين يعانون من الأمراض المزمنة وكبار السن بتأجيل العمرة والحج هذا العام، مع الحرص على الحصول على التطعيمات والإرشادات الصحية المناسبة.
ونصحت 'كبار السن' واصحاب الامراض المزمنة مثل أمراض القلب أو الكلى أو الأمراض الرئوية المزمنة أو غيرها من الأمراض المسببة لنقص المناعة بتأجيل العمرة والحج هذه السنة'، منوهة في الوقت ذاته المعتمرين من الكويت يطلب منهم فقط الحصول على تطعيمات الحمى الشوكية (السحائي)، والانفلونزا الموسمية ولقاح المكورات الرئوية.

تعليقات